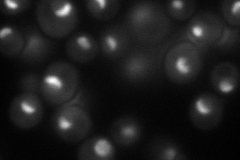
YCR057C
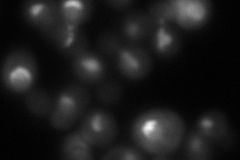
YCR057C

View description
Conserved 90S pre-ribosomal component essential for proper endonucleolytic cleavage of the 35 S rRNA precursor at A0, A1, and A2 sites; contains eight WD-repeats; PWP2 deletion leads to defects in cell cycle and bud morphogenesis
Localization:
Intensity:
Fold change:
Significance:
-
C’ GFP library in SD

nucleolus85.97 -
N' NOP1pr-GFP in SD
nucleolus83.8563 -
N' TEF2pr-mCherry in SD
nucleolusN/A -
N' NATIVEpr-GFP in SD

missing0 -
N' TEF2pr-VC and Cyto-VN in SD

nucleolus30.952 -
C’ GFP library in SD+DTT

nucleolus62.260.72No -
C’ GFP library in SD+H2O2

nucleolus77.750.9No -
C’ GFP library in Starvation Media

nucleolus58.320.67No -
C’ GFP library on the background of Pup2-DaMP

nucleolus -
C’ GFP library on the background of CCT mutant

nucleolus93.52111.08779No
